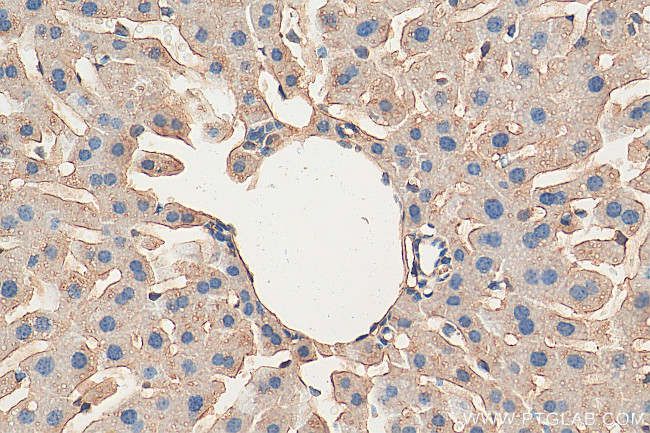
TRPS1 Antibody in Immunohistochemistry (Paraffin) (IHC (P))

Search
Proteintech
TRPS1 Polyclonal Antibody
{{$productOrderCtrl.translations['antibody.pdp.commerceCard.promotion.promotions']}}
{{$productOrderCtrl.translations['antibody.pdp.commerceCard.promotion.viewpromo']}}
{{$productOrderCtrl.translations['antibody.pdp.commerceCard.promotion.promocode']}}: {{promo.promoCode}} {{promo.promoTitle}} {{promo.promoDescription}}. {{$productOrderCtrl.translations['antibody.pdp.commerceCard.promotion.learnmore']}}
产品信息
21938-1-AP
种属反应
宿主/亚型
分类
类型
抗原
偶联物
形式
浓度
规格
纯化类型
保存液
内含物
保存条件
运输条件
产品详细信息
Immunogen sequence: LRNVASEGE GQILEPIGTE SKVSGKNKEF SADQMSENTD QSDAAELNHK EEHSLHVQDP SSSSKKDLKS AVLSEKAGFN YESPSKGGNF PSFPHDEVTD RNMLAFSSPA AGGVCEPLKS PQRAEADDPQ DMACTPSGDS LETKEDQKMS PKATEETGQA QSGQANCQGL SPVSVASKNP QVPSDGGVRL NKSKTDLLVN DNPDPAPLSP ELQDFKCNIC GYGYYGNDPT DLIKHFRKYH LGLHNRTRQD AELDSKILAL HNMVQFSHSK DFQKVNRSVF SGVLQDINSS RPVLLNGTYD VQVTSGGTFI GIGRKTPDCQ GNTKYFRCKF CNFTYMGNSS TELEQHFLQT H (9-358 aa encoded by BC125020)
靶标信息
This gene encodes a transcription factor that represses GATA-regulated genes and binds to a dynein light chain protein. Binding of the encoded protein to the dynein light chain protein affects binding to GATA consensus sequences and suppresses its transcriptional activity. Defects in this gene are a cause of tricho-rhino-phalangeal syndrome (TRPS) types I-III. [provided by RefSeq].
仅用于科研。不用于诊断过程。未经明确授权不得转售。
篇参考文献 (0)
生物信息学
蛋白别名: prostate cancer gene product; Tricho-rhino-phalangeal syndrome type I protein; trichorhinophalangeal syndrome I; trichorhinophalangeal syndrome I homolog; unnamed protein product; Zinc finger protein GC79; Zinc finger transcription factor Trps1
基因别名: AI115454; AI447310; D15Ertd586e; GC79; LGCR; TRPS1
UniProt ID: (Human) Q9UHF7
Entrez Gene ID: (Human) 7227, (Mouse) 83925, (Rat) 299897